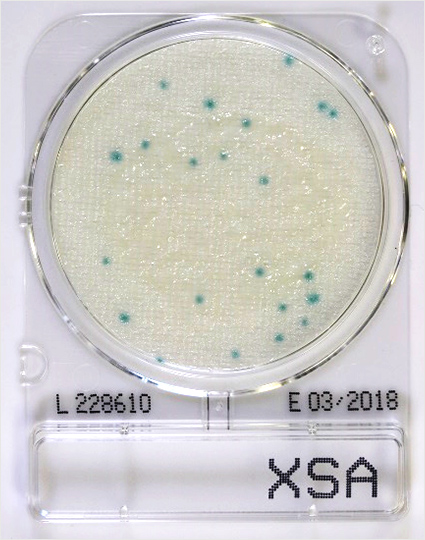
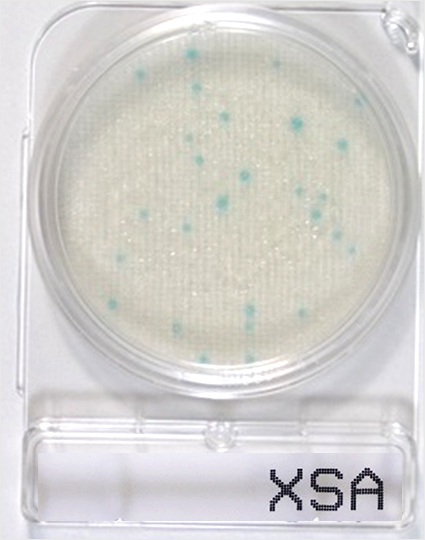
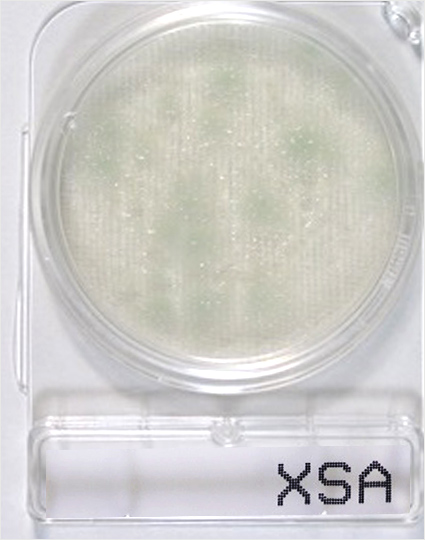
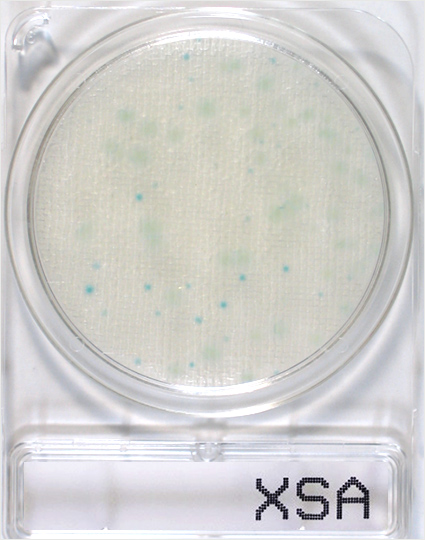
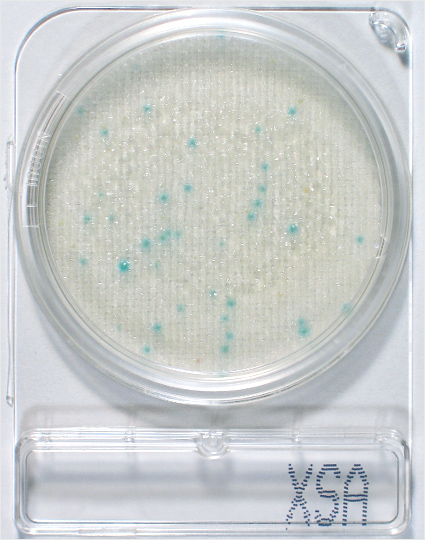
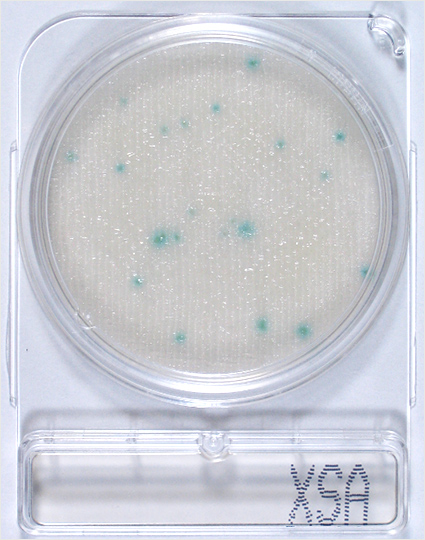
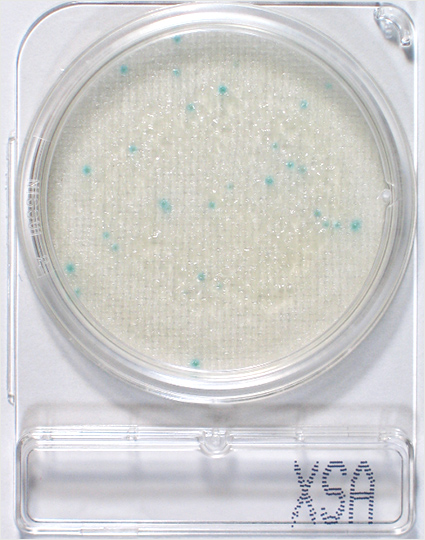

コンパクトドライ™ 判定ガイドコンパクトドライ™ X-SA
本ガイドは、コンパクトドライ™ X-SAの培養結果について適切に理解していただくためのものです。その他の製品については以下をご参照ください。
コンパクトドライ™ X-SA
| 用途 | 黄色ブドウ球菌測定用 |
|---|---|
| SA | Staphylococcus aureus |
| 認証 | 食品衛生検査指針2018収載/AOAC-PTM認証/MicroVal認証/NordVal認証 |
| 特長 | ・コロニーが発色するので、測定が簡単 |
| 判定方法 | 培養温度 37±1℃ 培養時間 24±2時間 黄色ブドウ球菌:水色~青色のコロニー |
※発色酵素基質により、黄色ブドウ球菌は水色〜青色のコロニーを形成します。
純培養菌を接種
Staphylococcus aureus (黄色ブドウ球菌)は、水色〜青色のコロニー、それ以外のStaphylococcus 属菌(表皮ブドウ球菌など)は、発育を抑制されるか、発育しても微小な白色コロニーを形成します。24時間を越えて培養すると表皮ブドウ球菌の白いコロニーが発色してきてしまいますので、培養時間は時間厳守してください。
一部のBacillus 属菌(特に、B. cereusとB. thuringiensisなど)は、すりガラス状の広がった薄い水色コロニーを形成することがあります。

黄色ブドウ球菌とBacillus 属菌を混合した菌液を接種して培養しました。
黄色ブドウ球菌は1~2 mmの比較的はっきりとした青い発色を示します。うっすらとした広がったコロニーは黄色ブドウ球菌ではありませんのでカウントから除外してください。

コンパクトドライに発育したコロニーを測定する際、白いボード(LEDトレース台)で裏からライトアップしますと、よりコロニーがはっきりと見えます。
いろいろな食品の培養例
各食品サンプルの10倍希釈液に黄色ブドウ球菌を接種し、37℃24時間培養しました。
手羽先の例では、青いコロニー(Staphylococcus aureus :黄色ブドウ球菌)のほかに、赤紫色系のコロニーが見られます。これらはBacillus 属などの菌が発育しているものと思われます。

鶏レバーでは、動物の内臓に含まれる酵素により緑色にシート全体が発色しています。滅菌生理食塩水などでさらに10倍希釈することで回避できます。

チーズを培養した例において、青色コロニー以外にやや褐色を帯び広がったコロニーが認められます。
これらもBacillus 属菌と思われます。